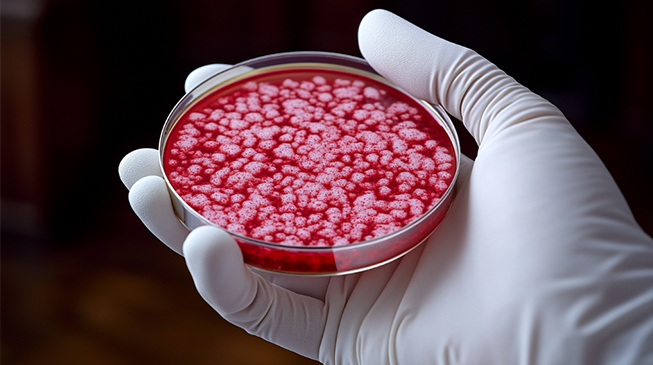

Особо опасна: сибирская язва
Многие слышали как в шутку зять называет тещу «сибирской язвой», и скорее всего каждый интуитивно понимает, что за этим «комплементом» явно не кроется ничего хорошего. А вот насколько он сомнительный как раз сейчас и разберемся!
Сибирская язва - особо опасное инфекционное заболевание, поражающее кожу, легкие и кишечник. Бактерия, которая вызывает это заболевание - Вacillus anthracis, очень хитрая и жизнелюбивая: как только ей что-то не по душе, она тут же превращается в спору и прекрасно переживает неблагоприятный период своего существования. В ожидании условий получше она может жить годами, выдерживая и высокие температуры, и замораживание, и действие дезинфицирующих средств.
Попадая в благоприятную среду, чаще всего в организм человека или животного, спора превращается в вегетативную форму, начинает активно размножаться и выделять токсин, запуская таким образом процесс заболевания. Именно поэтому бактерия так понравилась военным. Ведь это идеальное биологическое оружие для поражения максимального количества живых существ в минимальные сроки. Распылив споры сибирской язвы, можно на сотни лет загрязнить огромные территории до непригодного для жизни состояния. А из-за малого размера споры идеально проникают в легкие и стремительно поражают их. Но обо всем по порядку.
Начнем с того, как бактерия попадает в организм человека, а способов несколько.
Самый частый - контактный: через открытые повреждения на коже при уходе за больными сельскохозяйственными животными, забое и разделке туш, снятии шкур, контакте с шерстью, шкурой и другими продуктами животноводства, зараженными B. Anthracis.
Гораздо реже заражение происходит через воздух при вдыхании пыли со спорами бактерии и пищевым путем при употреблении мяса заражённого животного.
А что дальше? В зависимости от путей передачи выделяют четыре формы сибирской язвы: кожную, легочную, кишечную и септическую. К сожалению, только кожная форма может похвастаться частым благоприятным исходом, все остальные нередко заканчиваются смертью больного.
Спустя 2-14 дней после заражения у больных наблюдается сильнейшая интоксикация, сопровождающаяся головной болью, повышением температуры тела до 40 градусов, а через несколько дней - резким падением температуры ниже нормы. На коже появляются язвы, они безболезненны, что характерно для сибиреязвенного карбункула, а еще его отличительная черта - трехцветная окраска: в центре черный струп, вокруг желтоватая кайма, а далее – багровый широкий вал. При редких кишечной и легочной формах больные жалуются на кашель с кровью, одышку, боли в животе, тошноту, рвоту, жидкий стул с кровью.
На исход заболевания часто влияет своевременно начатое лечение, поэтому при первых симптомах рекомендуем обратиться к врачу.
Но, конечно, может возникнуть резонный вопрос: где обычный человек может столкнуться с больной коровой или разделкой туши овцы? Да и живем мы не в каменном веке: шкуры животных уже давно заменила нормальная одежда.
Именно поэтому выделяют группы людей, риск заболеть у которых гораздо выше, ведь по роду своей деятельности им ежедневно приходится сталкиваться и с больными животными, и с разделкой туш, а иногда и с возбудителем сибирской язвы: это сельскохозяйственные работники, работники животноводческих ферм, скотобоен и мясокомбинатов, кожевенных заводов, шерстомойных фабрик и цехов по изготовлению мясокостной муки и костного клея, врачи-ветеринары, сотрудники лабораторий, работающие с живыми культурами сибирской язвы.
В связи с повышенным риском заражения таким людям показана вакцинация против сибирской язвы. Первичная иммунизация проводится двукратно с интервалом 20 - 30 суток ревакцинация - ежегодно однократно.
Если вы не относитесь ни к одной из перечисленных групп населения, это не значит, что можно расслабиться. И хотя в России крайне редки случаи заражения сибирской язвой, меры предосторожности не помешают при контакте с дикими животными или при покупке мясных продуктов и шкур с рук в непроверенных местах.
Ну и в конце стоит сказать, почему язва «сибирская», неужели потому что ей болеют только в нашей стране? На самом деле нет, заболевание это распространено повсеместно, но вот сибирской язву называют только в России из-за преимущественного распространения в Сибири. А первым заболеванию дал такое название врач С. С. Андреевский, которому в 1785-1788 годах на Урале ценой собственного здоровья удалось сделать подробное описание сибирской язвы и разработать методы борьбы с инфекцией. Ну а нам, его потомкам, уже не нужно ничем жертвовать, достаточно лишь соблюдать меры профилактики и оставаться здоровыми.
Изображение сгенерировано с помощью нейросетей.